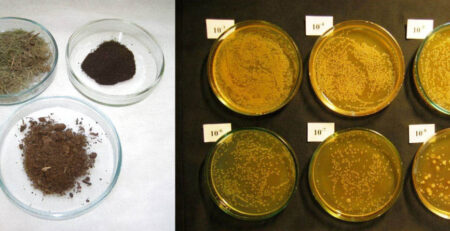
raksta vāka attēls Naftas absorbenti: definīcija un sastāvs

Kā meklēt naftu?
Pirmo posmu sauc par joku. Pirmais joks par potenciālajiem galamērķiem ir ielīmēt. Lai to izdarītu, majestātiskās teritorijas tiek aprīkotas ar vismodernāko tehniku: tās tiek fotografētas no kosmosa, “izgaismotas” ar seismiskiem vējiem un noklausītas ar īpašiem instrumentiem.
Speciālisti sastāda kartes un zīmē zemes garozas ģeoloģiskos šķērsgriezumus, kuros redzami virspusē esošie vigīna slāņi. Ja izrādās, ka zem zemes virsas atrodas kaut kas, kas atgādina potenciālo ogļhidrātu pastas sastāvu, sākas nākamais posms – ģints atklāšana.
Pirmais posms tiek veikts lielā ģeoloģiskās un ģeofizikālās izpētes teritorijā; tiek veikti references, parametriskie un Pošuka sverdlovinas urbumi.
Otrajā posmā tiek veikti urbumi, lai noskaidrotu, vai dziļumā ir nafta vai gāze un cik dziļi tā atrodas. Un tikai pēc tam, kad ir konstatēts un pierādīts, ka ģints augšana ir izdevīgāka, tiek uzsākta audzēšana.